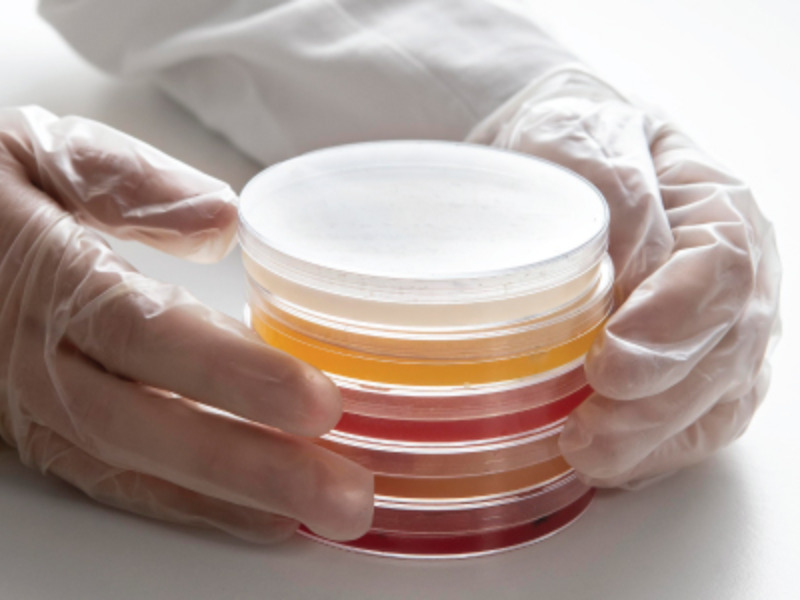
Lấy mẫu không khí chủ động
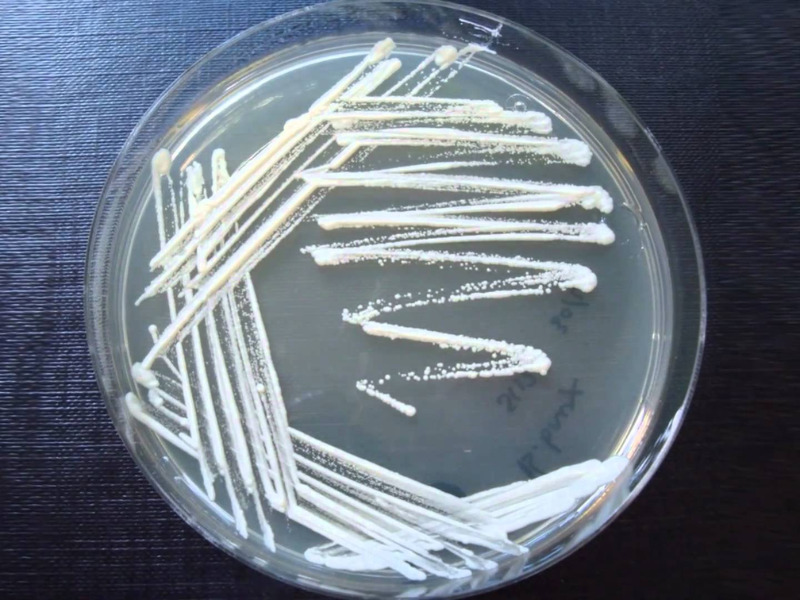
Lấy mẫu bề mặt (Đĩa RODAC)

Trong môi trường phòng sạch, kiểm soát vi sinh là yếu tố then chốt đảm bảo chất lượng và an toàn sản phẩm. Việc hiểu đúng tiêu chuẩn vi sinh phòng sạch giúp doanh nghiệp ngăn ngừa ô nhiễm và đáp ứng yêu cầu GMP, quốc tế. Bài viết sẽ cung cấp kiến thức cốt lõi và các phương pháp kiểm tra vi sinh hiệu quả.
Tiêu chuẩn vi sinh phòng sạch là gì?
Tiêu chuẩn vi sinh phòng sạch là hệ thống quy định giới hạn cho phép của vi sinh vật như vi khuẩn, nấm mốc trong không khí, trên bề mặt và trên người vận hành. Các tiêu chuẩn này được xây dựng nhằm đảm bảo môi trường sản xuất không gây nhiễm chéo, ảnh hưởng đến chất lượng sản phẩm và sức khỏe người tiêu dùng.

Tại sao phải tuân thủ tiêu chuẩn vi sinh phòng sạch?
Việc tuân thủ tiêu chuẩn vi sinh phòng sạch không chỉ là yêu cầu kỹ thuật bắt buộc mà còn là nền tảng đảm bảo an toàn, chất lượng và tính tuân thủ trong sản xuất hiện đại. Dưới đây là những lý do cốt lõi cho thấy vì sao doanh nghiệp cần kiểm soát vi sinh phòng sạch một cách nghiêm ngặt.
- Rủi ro từ ô nhiễm vi sinh: Ô nhiễm vi sinh trong phòng sạch có thể dẫn đến sản phẩm không đạt chất lượng, buộc phải tiêu hủy hoặc thu hồi. Điều này không chỉ gây thiệt hại tài chính mà còn ảnh hưởng nghiêm trọng đến uy tín và tính tuân thủ của doanh nghiệp.
- Yêu cầu tiêu chuẩn quốc tế: Các tiêu chuẩn quốc tế như GMP-WHO, EU-GMP hay FDA cGMP đều quy định chặt chẽ về tiêu chuẩn vi sinh phòng sạch. Việc không đáp ứng các yêu cầu này có thể khiến doanh nghiệp mất chứng nhận và gián đoạn hoạt động sản xuất.
- Bảo vệ sức khỏe người tiêu dùng: Kiểm soát tốt vi sinh giúp ngăn ngừa nguy cơ nhiễm khuẩn trong sản phẩm, đặc biệt với dược phẩm, thực phẩm và thiết bị y tế. Đây là yếu tố then chốt đảm bảo an toàn cho người sử dụng cuối cùng.
- Lợi ích kinh tế: Tuân thủ tiêu chuẩn vi sinh phòng sạch giúp giảm tỷ lệ lỗi, hạn chế lãng phí và tối ưu chi phí vận hành dài hạn. Đồng thời, doanh nghiệp nâng cao năng lực cạnh tranh và duy trì hoạt động ổn định, bền vững.

Sự khác biệt giữa kiểm soát hạt bụi và tiêu chuẩn vi sinh
Trong thực tế vận hành phòng sạch, nhiều doanh nghiệp thường nhầm lẫn giữa kiểm soát hạt bụi và tiêu chuẩn vi sinh phòng sạch. Việc hiểu rõ sự khác biệt giữa hai nội dung này giúp xây dựng hệ thống kiểm soát toàn diện, đảm bảo cả độ sạch vật lý lẫn an toàn vi sinh theo đúng yêu cầu kỹ thuật.
Phòng sạch và kiểm soát hạt bụi
Kiểm soát hạt bụi trong phòng sạch tập trung vào số lượng và kích thước hạt trong không khí theo tiêu chuẩn ISO 14644. Chỉ số này phản ánh mức độ sạch vật lý nhưng không đánh giá trực tiếp nguy cơ ô nhiễm vi sinh.
>> Xem thêm các tiêu chuẩn phòng sạch tại:
Tiêu chuẩn vi sinh và CFU (Colony Forming Units)
Tiêu chuẩn vi sinh phòng sạch đánh giá mức độ ô nhiễm sinh học thông qua chỉ số CFU, đại diện cho số vi sinh vật sống có khả năng phát triển. Đây là tiêu chí quan trọng nhằm kiểm soát vi khuẩn, nấm mốc và đảm bảo an toàn cho sản phẩm nhạy cảm.
CFU (Colony Forming Units) đại diện cho số lượng vi sinh vật sống có khả năng phát triển và hình thành khuẩn lạc, được dùng để ước tính mật độ vi khuẩn trong không khí hoặc trên bề mặt kiểm tra. Theo tiêu chuẩn GMP-WHO, giới hạn CFU được phân chia theo từng cấp độ phòng sạch nhằm kiểm soát mức độ ô nhiễm vi sinh phù hợp với mức độ rủi ro của từng khu vực sản xuất.
Tại sao cấp độ sạch theo hạt không phản ánh trạng thái vi sinh?
Cấp độ sạch theo hạt (ISO 14644) và trạng thái vi sinh là hai chiều kiểm soát độc lập – một phòng đạt chuẩn hạt hoàn toàn vẫn có thể thất bại về vi sinh.
Tiêu chuẩn ISO 14644-1 chỉ quy định nồng độ hạt bụi vật lý trong không khí theo kích thước (≥0,5 µm, ≥5 µm), hoàn toàn không đề cập đến vi sinh vật. Trong khi đó, tiêu chuẩn vi sinh (EU GMP Annex 1, ISO 14698) đo lường số vi sinh vật sống có khả năng sinh sôi – một đại lượng sinh học hoàn toàn khác với hạt vô sinh.
Ví dụ: Một phòng sạch ISO Class 5 cho phép tối đa 3.520 hạt ≥0,5 µm/m³ , hoàn toàn đạt chuẩn hạt. Tuy nhiên nếu không có chương trình kiểm soát vi sinh, phòng đó hoàn toàn có thể chứa >1.000 CFU/m³ vi khuẩn, vượt ngưỡng cho phép của Grade A (<1 CFU/m³) gấp hơn 1.000 lần.
Tiêu chuẩn vi sinh phòng sạch theo GMP-WHO
Tiêu chuẩn vi sinh phòng sạch theo GMP-WHO là cơ sở quan trọng để đánh giá mức độ an toàn vi sinh trong môi trường sản xuất dược phẩm và phòng sạch. Việc tuân thủ các giới hạn vi sinh theo GMP-WHO giúp doanh nghiệp kiểm soát rủi ro ô nhiễm và đáp ứng yêu cầu kỹ thuật quốc tế. Tiêu chuẩn vi sinh phòng sạch GMP-WHO còn phân biệt rõ điều kiện đánh giá nhằm phản ánh chính xác trạng thái thực tế của phòng sạch trong từng thời điểm.
Tiêu chuẩn trong hoạt động (In operation): Đánh giá mức độ ô nhiễm vi sinh khi phòng sạch đang vận hành, có nhân sự và thiết bị hoạt động. Chỉ số này phản ánh rủi ro vi sinh trong điều kiện sản xuất thực tế.
| Cấp độ | Không khí (CFU/m³) | Bề mặt (CFU/9 cm²) | Đặc điểm khu vực |
| Grade A | < 1 | < 1 | Duy trì ngưỡng tuyệt đối ngay cả khi đang sản xuất |
| Grade B | ≤ 10 | < 5 | Kiểm soát rất chặt khi có nhân sự – rủi ro lây nhiễm chéo thấp |
| Grade C | ≤ 100 | < 25 | Cho phép mức ô nhiễm cao hơn at rest – giám sát định kỳ bắt buộc |
| Grade D | ≤ 200 | < 50 | Ngưỡng thực tế cao nhất – phù hợp khu vực chuẩn bị nguyên liệu |
Tiêu chuẩn tại chỗ (At rest): Đánh giá vi sinh khi phòng sạch đã hoàn tất vệ sinh, không có hoạt động sản xuất và nhân sự. Đây là cơ sở để xác nhận điều kiện nền của phòng sạch trước khi đưa vào vận hành.
| Cấp độ | Không khí (CFU/m³) | Bề mặt (CFU/9 cm²) | Đặc điểm khu vực |
| Grade A | < 1 | < 1 | Khu vực vô trùng quan trọng – tiêu chuẩn nền gần tuyệt đối |
| Grade B | ≤ 10 | < 5 | Khu vực hỗ trợ Grade A – điều kiện nền gần tương đương Grade A |
| Grade C | ≤ 10 | < 25 | Khu vực sản xuất ít nhạy cảm – điều kiện nền kiểm soát tốt |
| Grade D | ≤ 100 | < 50 | Khu vực phụ trợ – điều kiện nền sau làm sạch đạt mức cơ bản |
Tiêu chuẩn vi sinh phòng sạch quốc tế
Bên cạnh GMP-WHO, tiêu chuẩn vi sinh phòng sạch còn được quy định bởi nhiều chuẩn quốc tế quan trọng. Dưới đây là các tiêu chuẩn phổ biến doanh nghiệp thường áp dụng.
Tiêu chuẩn EU-GMP
EU-GMP quy định chặt chẽ việc kiểm soát vi sinh trong phòng sạch, đặc biệt với các khu vực sản xuất vô trùng. Tiêu chuẩn này yêu cầu giám sát định kỳ và xử lý kịp thời khi vượt ngưỡng cho phép.

Tiêu chuẩn FDA cGMP (Mỹ)
FDA cGMP tập trung kiểm soát vi sinh xuyên suốt toàn bộ quá trình sản xuất, từ môi trường, thiết bị đến con người. Việc tuân thủ giúp doanh nghiệp đáp ứng yêu cầu lưu hành và xuất khẩu sản phẩm sang thị trường Mỹ.

Tiêu chuẩn ISO 14698
ISO 14698 cung cấp hướng dẫn chuyên biệt về kiểm soát ô nhiễm sinh học trong phòng sạch. Tiêu chuẩn này hỗ trợ doanh nghiệp xây dựng chương trình đánh giá rủi ro và giám sát vi sinh một cách hệ thống.

Các phương pháp kiểm tra vi sinh phòng sạch đạt chuẩn
Việc đánh giá chính xác mức độ ô nhiễm vi sinh là bước quan trọng để duy trì điều kiện phòng sạch đạt chuẩn. Dưới đây là các phương pháp kiểm tra vi sinh thường được sử dụng nhằm đáp ứng yêu cầu kỹ thuật và giám sát hiệu quả.
Lấy mẫu không khí chủ động
Thiết bị lấy mẫu chủ động (thường là impactor hoặc RCS sampler) hút một thể tích không khí đã được định lượng chính xác (tính bằng lít hoặc m³) qua đĩa/môi trường nuôi cấy (TSA, SDA…). Vi sinh vật trong không khí va đập và bám lên bề mặt thạch, sau đó được ủ và đếm khuẩn lạc.
Các bước thực hiện:
- Hiệu chỉnh lưu lượng hút (thường 100–200 L/phút), kiểm tra pin/nguồn, đảm bảo đầu hút đã được khử trùng.
- Xác định điểm lấy mẫu theo bản đồ phòng sạch (gần khu vực thao tác, tại độ cao làm việc ~1–1,2 m).
- Đặt đĩa thạch vào đầu lấy mẫu, ghi nhận thông tin mẫu (vị trí, thời gian, lô thạch).
- Kích hoạt thiết bị, hút đúng thể tích quy định (VD: 1.000 L theo ISO 14698-1). Tránh tạo luồng khí bất thường trong quá trình hút.
- Đậy nắp đĩa ngay sau khi lấy mẫu, ghi nhãn đầy đủ, bảo quản lạnh (2–8°C) nếu chưa ủ ngay.
- Ủ đĩa theo điều kiện quy định (vi khuẩn: 30–35°C/48–72h; nấm mốc: 20–25°C/5–7 ngày). Đếm số khuẩn lạc (CFU).
Lấy mẫu không khí thụ động
Đĩa thạch mở (thường là TSA hoặc SDA, đường kính 90 mm) được đặt tại các vị trí quy định trong phòng sạch. Vi sinh vật lơ lửng trong không khí tự nhiên rơi lắng xuống bề mặt thạch theo trọng lực. Sau thời gian phơi mẫu, đĩa được ủ và đếm khuẩn lạc để đánh giá mức độ ô nhiễm sinh học trong môi trường vận hành.\
Các bước thực hiện:
- Kiểm tra hạn sử dụng, ngoại quan (không nứt vỡ, không nhiễm trước), ghi nhãn đầy đủ (vị trí, ngày giờ, loại môi trường).
- Bố trí theo bản đồ lấy mẫu đã phê duyệt, ưu tiên gần khu vực thao tác quan trọng, tại độ cao bề mặt làm việc (~0,8–1 m).
- Mở nắp đĩa, đặt ngửa, ghi nhận thời điểm bắt đầu. Thời gian phơi chuẩn thường là 4 giờ (theo EU GMP Annex 1) hoặc theo quy trình nội bộ, nhưng không quá 4 giờ để tránh đĩa bị khô.
- Đậy nắp ngay khi hết thời gian, ghi nhận thời điểm kết thúc. Tránh chạm tay vào bề mặt thạch.
- Bảo quản ở 2–8°C nếu chưa ủ ngay, thời gian tối đa từ khi lấy đến khi ủ thường không quá 24 giờ.
- Ủ đĩa và quan sát: Vi khuẩn: 30–35°C trong 48–72 giờ; Nấm mốc/nấm men: 20–25°C trong 5–7 ngày. Đọc và đếm khuẩn lạc (CFU/đĩa).
- Kết quả ghi theo đơn vị CFU/đĩa/4h. So sánh với Alert Limit và Action Limit theo cấp phòng sạch tương ứng (EU GMP Grade A–D hoặc ISO 5–8).
Lấy mẫu bề mặt bằng tăm bông (Surface Swabbing)
Tăm bông vô trùng được làm ẩm bằng dung dịch pha loãng trung hòa (neutralizing buffer hoặc nước muối sinh lý 0,9%) rồi quét trực tiếp lên bề mặt cần kiểm tra. Vi sinh vật bám trên bề mặt sẽ bám lên đầu tăm bông, sau đó được giải phóng vào dung dịch, cấy lên môi trường nuôi cấy và đếm khuẩn lạc. Đây là phương pháp đặc biệt hiệu quả với bề mặt cong, góc khuất, mối hàn, khe hở — những nơi đĩa tiếp xúc (contact plate) không thể với tới.
Các bước thực hiện:
- Chuẩn bị: Tăm bông vô trùng (swab đơn lẻ đóng gói), dung dịch làm ẩm (neutralizing buffer phù hợp với chất khử trùng đang dùng), template khung định vị diện tích lấy mẫu (thường 25 cm² hoặc 100 cm²).
- Xác định vị trí lấy mẫu, ưu tiên bề mặt tiếp xúc trực tiếp với sản phẩm: bàn thao tác, tay nắm, thành trong thiết bị, mối hàn, van, góc tủ LAF. Ghi nhận tọa độ theo bản đồ lấy mẫu đã phê duyệt.
- Nhúng đầu tăm bông vào dung dịch pha loãng, vẩy nhẹ để loại bỏ phần dư thừa (tăm bông ẩm đều, không nhỏ giọt).
- Đặt template lên bề mặt (nếu dùng). Quét tăm bông theo kỹ thuật chữ Z hoặc S: quét ngang từ trái sang phải, xoay tăm bông 90°, quét dọc từ trên xuống, đảm bảo toàn bộ diện tích được phủ đều. Dùng lực vừa phải, không quét quá nhẹ.
- Gập hoặc cắt phần tay cầm, đặt đầu tăm bông vào ống chứa dung dịch pha loãng đã chuẩn bị. Đậy nắp, ghi nhãn đầy đủ (vị trí, diện tích, thời gian, người lấy mẫu).
- Vận chuyển và xử lý, bảo quản 2–8°C, xử lý trong vòng 4 giờ (tối đa không quá 24 giờ). Vortex ống mẫu 30 giây để giải phóng vi sinh vật khỏi đầu tăm bông, sau đó cấy lên đĩa thạch hoặc lọc màng.
- Ủ và đọc kết quả: Vi khuẩn: 30–35°C/48–72h; Nấm mốc: 20–25°C/5–7 ngày. Kết quả tính theo CFU/cm² (chia tổng CFU cho diện tích lấy mẫu).

Lấy mẫu bề mặt (Đĩa RODAC)
Đĩa RODAC (Replicate Organism Detection And Counting) là đĩa thạch lồi đặc biệt — bề mặt thạch nhô cao hơn miệng đĩa để tiếp xúc trực tiếp với bề mặt cần kiểm tra khi ấn xuống. Vi sinh vật bám trên bề mặt sẽ in lên thạch, sau đó được ủ và đếm khuẩn lạc. Diện tích tiếp xúc chuẩn là 25 cm², cho phép tính kết quả trực tiếp theo CFU/25 cm² mà không cần bước xử lý trung gian.
Các bước thực hiện:
- Chuẩn bị đĩa RODAC – Kiểm tra hạn sử dụng, ngoại quan thạch (không nứt, không co rút, không nhiễm trước). Đảm bảo môi trường phù hợp: TSA cho vi khuẩn tổng số, SDA cho nấm mốc/nấm men. Để đĩa cân bằng về nhiệt độ phòng trước khi dùng.
- Xác định vị trí lấy mẫu – Ưu tiên bề mặt phẳng tiếp xúc trực tiếp với sản phẩm: bàn thao tác, băng tải, thành trong tủ LAF, sàn khu vực điểm kiểm soát tới hạn. Ghi nhận theo bản đồ lấy mẫu đã phê duyệt.
- Mở nắp và áp đĩa – Mở nắp bảo vệ, ấn nhẹ và đều mặt thạch lên bề mặt cần lấy mẫu trong 10 giây. Dùng ngón tay ấn đều lên đáy đĩa để đảm bảo toàn bộ 25 cm² tiếp xúc hoàn toàn — tránh ấn lệch hoặc trượt làm nhòe kết quả.
- Thu hồi đĩa – Nhấc đĩa thẳng đứng, đậy nắp ngay lập tức. Ghi nhãn đầy đủ (vị trí, bề mặt vật liệu, thời gian, người lấy mẫu).
- Lau sạch dư lượng thạch – Sau khi lấy mẫu, lau bề mặt tiếp xúc bằng cồn 70% để loại bỏ dư lượng chất dinh dưỡng từ thạch, tránh tạo điều kiện cho vi sinh phát triển.
- Ủ và đọc kết quả – Vi khuẩn: 30–35°C/48–72h; Nấm mốc: 20–25°C/5–7 ngày. Đếm trực tiếp khuẩn lạc trên đĩa, kết quả ghi theo CFU/25 cm². So sánh với giới hạn Alert và Action Limit theo cấp phòng sạch.
Ưu điểm và giới hạn cần lưu ý:
- Thao tác nhanh, đơn giản, không cần thiết bị phụ trợ.
- Diện tích lấy mẫu chuẩn hóa 25 cm² giúp kết quả dễ so sánh và báo cáo.
- Phù hợp để đánh giá hiệu quả vệ sinh sau mỗi ca sản xuất hoặc sau clean validation.
- Chỉ áp dụng được cho bề mặt phẳng — không dùng được cho bề mặt cong, góc khuất, khe hở (cần kết hợp với swabbing).
- Dư lượng thạch để lại trên bề mặt nếu không lau sạch có thể gây ô nhiễm thứ cấp.
Kiểm tra vi sinh găng tay
Găng tay của người vận hành là một trong những nguồn ô nhiễm vi sinh hàng đầu trong phòng sạch, đặc biệt tại các khu vực sản xuất vô trùng (EU GMP Grade A/B, ISO 5). Kiểm tra găng tay được thực hiện bằng cách ấn trực tiếp đầu ngón tay lên đĩa thạch RODAC hoặc dùng swab quét bề mặt găng — nhằm phát hiện vi sinh vật từ da tay thẩm thấu qua hoặc tích tụ bên ngoài găng trong quá trình thao tác.
Các bước thực hiện:
- Xác định thời điểm kiểm tra – Thực hiện trong hoặc ngay sau ca sản xuất, không báo trước cho người vận hành để phản ánh đúng thực trạng. Có thể kiểm tra định kỳ (mỗi ca, mỗi tuần) hoặc sau sự kiện bất thường (rách găng, tiếp xúc bề mặt không sạch).
- Chuẩn bị đĩa RODAC – Dùng đĩa TSA (vi khuẩn) hoặc SDA (nấm mốc), để cân bằng nhiệt độ phòng. Ghi nhãn sẵn: tên/mã người vận hành, tay trái/phải, thời gian.
- Lấy mẫu ngón tay – Người vận hành ấn nhẹ 5 đầu ngón tay lên bề mặt thạch của một đĩa RODAC trong khoảng 10 giây. Giữ nguyên vị trí, không trượt. Thông thường lấy mẫu cả hai tay — mỗi tay một đĩa.
- Thu hồi đĩa – Đậy nắp ngay, ghi nhận đầy đủ thông tin. Người vận hành tiếp tục công việc bình thường hoặc thay găng mới nếu quy trình yêu cầu.
- Ủ và đọc kết quả – Vi khuẩn: 30–35°C/48–72h; Nấm mốc: 20–25°C/5–7 ngày. Đếm tổng số khuẩn lạc trên đĩa, kết quả ghi theo CFU/đĩa (5 ngón tay).
- Đánh giá và xử lý – So sánh với giới hạn quy định:
- Grade A/ISO 5: Alert Limit < 1 CFU/đĩa, Action Limit ≥ 1 CFU/đĩa
- Grade B/ISO 6: Alert Limit ≤ 5 CFU/đĩa, Action Limit > 5 CFU/đĩa
>> Xem thêm: Găng tay phòng sạch là gì?

Quy trình thiết lập tiêu chuẩn vi sinh phòng sạch
Việc xây dựng quy trình kiểm soát vi sinh rõ ràng là bước nền tảng để phòng sạch vận hành đúng chuẩn. Dưới đây là các giai đoạn cần thiết khi thiết lập và duy trì tiêu chuẩn vi sinh phòng sạch trong thực tế sản xuất.
Giai đoạn 1 – Đánh giá rủi ro
Doanh nghiệp xác định các khu vực, công đoạn và yếu tố có nguy cơ ô nhiễm vi sinh cao. Bước này giúp ưu tiên nguồn lực và xây dựng mức kiểm soát phù hợp với từng cấp độ phòng sạch.
Giai đoạn 2 – Lập kế hoạch giám sát
Thiết lập kế hoạch kiểm tra vi sinh chi tiết, bao gồm vị trí lấy mẫu, phương pháp, tần suất và giới hạn cho phép. Kế hoạch cần phù hợp với tiêu chuẩn vi sinh phòng sạch và yêu cầu GMP áp dụng.
Giai đoạn 3 – Thực hiện giám sát
Tiến hành lấy mẫu và kiểm tra vi sinh theo đúng kế hoạch đã xây dựng. Việc thực hiện nhất quán giúp theo dõi xu hướng ô nhiễm và phát hiện sớm các dấu hiệu bất thường.
Giai đoạn 4 – Đánh giá và hành động
Phân tích kết quả kiểm tra, so sánh với giới hạn cho phép và đưa ra hành động khắc phục khi cần thiết. Đây là bước quan trọng để duy trì và cải tiến liên tục hệ thống kiểm soát vi sinh.

Lưu ý khi kiểm soát không khí phòng sạch
Không khí là nguồn mang vi sinh chính trong môi trường phòng sạch, vì vậy việc kiểm soát đúng cách đóng vai trò quyết định hiệu quả của tiêu chuẩn vi sinh phòng sạch. Dưới đây là những điểm cần đặc biệt lưu ý trong quá trình vận hành và giám sát không khí phòng sạch.
Duy trì dòng không khí: Dòng không khí trong phòng sạch cần được thiết kế và duy trì ổn định theo đúng tiêu chuẩn, đảm bảo luồng khí sạch đi từ khu vực sạch hơn sang khu vực kém sạch hơn. Việc kiểm soát tốt dòng khí giúp hạn chế tích tụ vi sinh và bụi bẩn trong khu vực sản xuất.
Khử trùng và lọc không khí: Hệ thống lọc HEPA hoặc ULPA cần được kiểm tra và bảo trì định kỳ để đảm bảo hiệu quả loại bỏ hạt và vi sinh. Kết hợp khử trùng không khí đúng quy trình giúp duy trì điều kiện phòng sạch đáp ứng tiêu chuẩn vi sinh phòng sạch.
Ngăn ngừa lây nhiễm chéo: Kiểm soát sự di chuyển của con người, vật tư và thiết bị là yếu tố quan trọng để ngăn ngừa lây nhiễm chéo. Trang phục phòng sạch, quy trình ra vào và phân luồng rõ ràng giúp giảm thiểu nguy cơ đưa vi sinh vào khu vực sạch.
Câu hỏi thường gặp về tiêu chuẩn vi sinh
Trong quá trình áp dụng tiêu chuẩn vi sinh phòng sạch, nhiều doanh nghiệp vẫn còn những thắc mắc liên quan đến tần suất kiểm tra, chi phí và cách vận hành phòng sạch đúng chuẩn. Dưới đây là các câu hỏi phổ biến giúp làm rõ những vấn đề thường gặp trong thực tế.
Tiêu chuẩn vi sinh phòng sạch được kiểm tra bao lâu?
Tần suất kiểm tra phụ thuộc vào cấp độ phòng sạch, mức độ rủi ro và yêu cầu GMP áp dụng. Với các khu vực quan trọng, việc kiểm tra có thể thực hiện hàng ngày hoặc hàng tuần để đảm bảo tuân thủ tiêu chuẩn vi sinh phòng sạch.
Làm thế nào để biết phòng sạch bị ô nhiễm?
Phòng sạch được xem là ô nhiễm khi kết quả kiểm tra CFU vượt quá giới hạn cho phép. Ngoài ra, các dấu hiệu như mùi bất thường, tăng tỷ lệ lỗi sản phẩm cũng cần được xem xét.
Chi phí kiểm tra vi sinh cao không?
Chi phí kiểm tra vi sinh phụ thuộc vào phương pháp, tần suất và số lượng điểm lấy mẫu. So với rủi ro sản xuất lỗi hoặc thu hồi sản phẩm, chi phí này được đánh giá là hợp lý và cần thiết.
Phòng sạch Grade A và B có thể chứa cùng nhân viên không?
Có thể, nhưng nhân viên phải tuân thủ quy trình di chuyển và thay trang phục nghiêm ngặt. Điều này nhằm tránh lây nhiễm chéo và đảm bảo tiêu chuẩn vi sinh phòng sạch cho từng khu vực.
Trong hành trình kiểm soát chất lượng sản xuất, tiêu chuẩn vi sinh phòng sạch đóng vai trò như “hàng rào an toàn” bảo vệ sản phẩm, con người và uy tín doanh nghiệp. Việc áp dụng đúng tiêu chuẩn vi sinh phòng sạch giúp hạn chế ô nhiễm vi sinh, đáp ứng yêu cầu GMP – quốc tế và tạo nền tảng vận hành ổn định, bền vững trong dài hạn.
Để triển khai hiệu quả tiêu chuẩn vi sinh phòng sạch, doanh nghiệp cần hệ thống vật tư phòng sạch và trang bị bảo hộ đạt chuẩn ngay từ đầu. Chuki Safety là đơn vị đồng hành tin cậy, chuyên cung cấp giải pháp vật tư phòng sạch và bảo hộ lao động đáp ứng yêu cầu kiểm soát vi sinh nghiêm ngặt.

